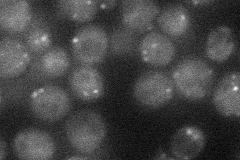
YLL057C
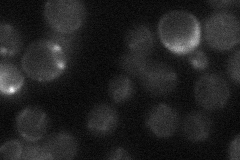
YLL057C
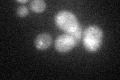
YLL057C

View description
Fe(II)-dependent sulfonate/alpha-ketoglutarate dioxygenase, involved in sulfonate catabolism for use as a sulfur source; contains sequence that resembles a J domain (typified by the E. coli DnaJ protein); induced by sulphur starvation
Localization:
Intensity:
Fold change:
Significance:
-
C’ GFP library in SD

below threshold16.43 -
N' NOP1pr-GFP in SD
punctate23.9198 -
N' TEF2pr-mCherry in SD

below threshold5.89752 -
N' NATIVEpr-GFP in SD
below threshold16.3865 -
N' TEF2pr-VC and Cyto-VN in SD

#N/A0 -
C’ GFP library in SD+DTT
cytosol17.421.06No -
C’ GFP library in SD+H2O2

cytosol18.691.13No -
C’ GFP library in Starvation Media

cytosol16.511No -
C’ GFP library on the background of Pup2-DaMP

below threshold -
C’ GFP library on the background of CCT mutant

below threshold16.68861.01539No
